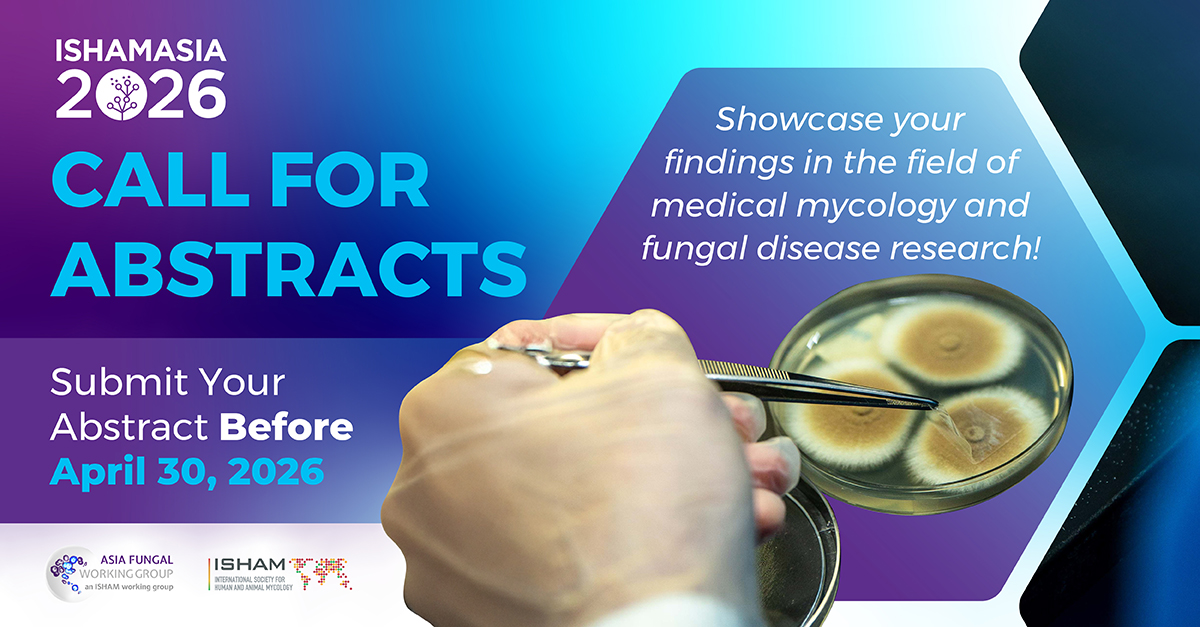
Asia Fungal Working Group (AFWG) tweet media

Bin Lin retweetledi

The ESCMID Mobile Lab returns to #ESCMIDGlobal2026, offering new sessions on digital PCR #dPCR, with equipment supplied by Bio-Rad. There's something for all levels: beginners, intermediate & advanced. Learn more about the new sessions and sign up today: ow.ly/YN6Q50YCcaE

English